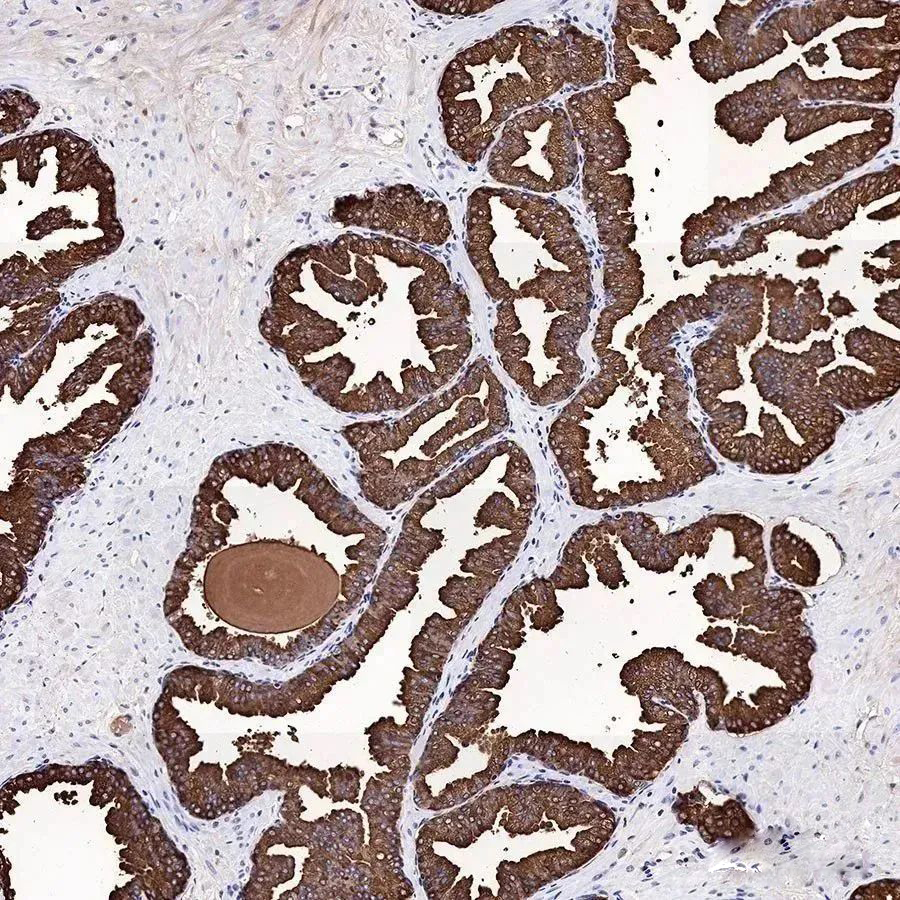
技术资料图片2

2 年
手机商铺
技术资料/正文
69 人阅读发布时间:2025-06-09 09:41
前列腺癌的IHC检测是一种通过免疫组化(IHC)技术来检测前列腺癌的方法。IHC技术利用抗原抗体结合的原理,通过标记有显色剂的抗体与组织中特定的抗原结合,从而在显微镜下观察到病理变化。
在前列腺癌的IHC检测中,常用的抗体包括前列腺特异性抗原(PSA)抗体、AMACR抗体、P504S抗体等。其中,PSA抗体是最常用的抗体之一,它能够检测前列腺上皮细胞中的PSA蛋白,帮助确定肿瘤的性质和来源。
通过IHC检测,医生可以更准确地诊断前列腺癌,确定肿瘤的范围和恶性程度,为制定进一步的治疗方案提供依据。
斯达特目前推出了多种前列腺癌的IHC检测生物标志物。这些标志物已经在IHC-P、WB等多个平台上进行了应用验证。

常见前列腺癌IHC检测生物标志物
1、PSA
PSA,前列腺特异性抗原。它是由前列腺泡及导管细胞分泌的一种丝氨酸蛋白酶,直接分泌到前列腺导管内。PSA作为前列腺癌的肿瘤标志物被广泛应用。在临床应用中PSA 是作为早期发现和筛选早期前列腺癌非常有价值的指标。
抗体名称:PSA Recombinant Rabbit mAb
组织类型:人前列腺增生
IHC染色定位:分泌
抗原修复液:Tris/EDTA (pH 9.0)
修复方式:高温高压
2、PSMA
PSMA有几个不同的名称:谷氨酸羧肽酶II(GCPII)、N乙酰化α连接酸性二肽酶,叶酸水解酶(FOLH1)——反映了该酶在不同组织中的活性。该蛋白也被称为前列腺特异性膜抗原,在前列腺癌细胞上高度并选择性表达,被用作前列腺癌的诊断和预后指标。

抗体名称:PSMA Recombinant Rabbit mAb
组织类型:人前列腺癌
IHC染色定位:细胞膜,细胞质
抗原修复液:Tris/EDTA (pH 9.0)
修复方式:高温高压
3、CK-HMW
CK(HMW)是一种高分子量的细胞角蛋白。在鳞状上皮、导管上皮、分层上皮、前列腺基底细胞和乳腺肌上皮细胞中表达。它是前列腺基底细胞的特异性标记,它与p63和AMACR联合用于诊断前列腺良性和恶性病变。它还可用于鉴别尿路上皮异性增生和原位癌。

抗体名称:CK-HMW Recombinant Rabbit mAb
组织类型:人前列腺
IHC染色定位:细胞质
抗原修复液:Tris/EDTA (pH 9.0)
修复方式:高温高压
StarMab®相关产品
点击下方的产品货号,直达官网详情页供您了解。



杭州斯达特 (www.starter-bio.com)志在为全球生命科学行业提供优质的抗体、蛋白、试剂盒等产品及研发服务。依托多个开发平台:重组兔单抗、重组鼠单抗、快速鼠单抗、重组蛋白开发平台(E.coli,CHO,HEK293,InsectCells),已正式通过欧盟98/79/EC认证、ISO9001认证、ISO13485。